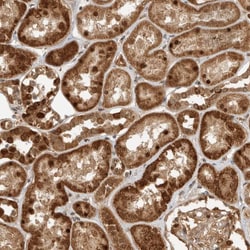
Invitrogen DCAF8 Polyclonal Antibody 100 &mu;L | Buy Online | Invitrogen&trade; | Fisher Scientific

missing translation for 'onlineSavingsMsg'
Learn More
Learn More
Beschreibung
Immunogen sequence: EDKDSDSMED TGHYSINDEN RVHDRSEEEE EEEEEEEEEQ PRRRVQRKRA NRDQDSSDDE RALEDWVS Highest antigen sequence identity to the following orthologs: Mouse - 75%, Rat - 82%.
This gene encodes a WD repeat-containing protein that interacts with the Cul4-Ddb1 E3 ligase macromolecular complex. Multiple alternatively spliced transcript variants have been found for this gene.

Spezifikation
Spezifikation
| Antigen | DCAF8 |
| Anwendungen | Immunohistochemistry (Paraffin), Western Blot, Immunocytochemistry |
| Klassifikation | Polyclonal |
| Konzentration | 0.1 mg/mL |
| Konjugat | Unconjugated |
| Zusammensetzung | PBS with 40% glycerol and 0.02% sodium azide; pH 7.2 |
| Gen | DCAF8 |
| Gen-Zugriffsnummer | Q5TAQ9 |
| Gen-Alias | AA408877; AA433120; AA792214; AU018973; C76055; D1Dau35e; D1Ucla4; Dcaf8; DDB1 and CUL4 associated factor 8; DDB1- and CUL4-associated factor 8; GAN2; H326; WD repeat domain 42A; WD repeat-containing protein 42A; Wdr42a |
| Gensymbole | DCAF8 |
| Mehr anzeigen |
Name des Produkts
Indem Sie auf Absenden klicken, erklären Sie sich damit einverstanden, dass Fisher Scientific sich mit Ihnen in Verbindung setzen kann, um Ihr Feedback in diesem Formular zu bearbeiten. Wir werden Ihre Informationen nicht für andere Zwecke weitergeben. Alle bereitgestellten Kontaktinformationen werden in Übereinstimmung mit unserer Datenschutzrichtlinie aufbewahrt. Datenschutzrichtlinie.
Haben Sie Verbesserungsvorschläge?